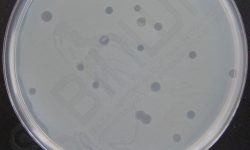
Bakteriofag

Celem projektu jest digitalizacja unikalnych zasobów naukowych IITD PAN oraz utworzenie platformy BINWIT, której wdrożenie umożliwi cyfrowe udostępnienie informacji o kolekcji bakteriofagów, ich sekwencji nukleotydowej oraz informacji o biologii komórek macierzystych o przełomowym znaczeniu dla zidentyfikowanej grupy interesariuszy:
- Lekarzy (m.in. w medycynie regeneracyjnej, transplantacyjnej, estetycznej) oraz zajmujących się leczeniem zakażeń wywołanych przez antybiotykooporne bakterie;
- Naukowców i wykładowców instytutów naukowych oraz badawczych i uniwersytetów medycznych
- Studentów uczelni medycznych, studentów kierunków związanych z mikrobiologią i biotechnologią (Life science)
- Ponadśrodowiskowej grupy odbiorców poszukującej informacji naukowych o innowacyjnych terapiach (pacjentów z opornymi na antybiotykoterapię zakażeniami bakteryjnymi, pacjentów medycyny regeneracyjnej i estetycznej).
BAZA INFORMACJI NAUKOWYCH
WSPIERAJĄCYCH INNOWACYJNE TERAPIE
PRZYKŁADY ZASOBÓW WYSZUKIWARKI BINWIT

Komórki MSC z tkanki tłuszczowej
Różnicowanie adipogenne komórek MSC izolowanych z tkanki tłuszczowej w pasażu P3, po 14 dniach hodowli w medium różnicującym. Barwienie czerwienią oleistą uwidoczniło powstanie licznych adipocytów

Chondrogeneza komórek MSC izolowanych z tkanki tłuszczowej
Barwienie błękitem alcjańskim hodowli komórek MSC izolowanych z tkanki tłuszczowej człowieka w pasażu P1 po 14 dniach różnicowania w chondrogennej pożywce hodowlanej. Błękitne zabarwienie świadczy o formowaniu tkanki chrzęstnej.

Osteogeneza komórek MSC izolowanych z tkanki tłuszczowej
Barwienie czerwienią alizarynową hodowli komórek MSC izolowanych z tkanki tłuszczowej człowieka po 14 dniach różnicowania w osteogennej pożywce hodowlanej. Czerwone zabarwienie sugeruje powstawanie komórek kościotwórczych. Powiększenie x200.

Adipogeneza komórek MSC
Różnicowanie adipogenne komórek MSC izolowanych z tkanki tłuszczowej w pasażu P6, po 14 dniach hodowli w medium różnicującym. Barwienie czerwienią oleistą uwidoczniło powstanie licznych adipocytów. Powiększenie x200.
AKTUALNOŚCI
Jak przebiega sekwencjonowanie nanoporowe
Film prezentuje najnowszą technologię sekwencjonowania DNA.
Jak działa transmisyjny mikroskop elektronowy
Film prezentuje zasadę działania transmisyjnego mikroskopu elektronowego.
Czym są komórki macierzyste?
W tym filmie dowiesz się czym są komórki macierzyste, jak się dzielą i gdzie mogą zostać zastosowane.
Wywiad z profesorem doktorem hab. Andrzejem Górskim, przeprowadzony w IITD PAN we Wrocławiu
Prezentujemy wywiad z profesorem doktorem hab. Andrzejem Górskim, przeprowadzony 15.10.2021 r. w IITD PAN we Wrocławiu przez dziennikarza naukowego Jarosława Juszkiewicza.
Konferencja “Baza Informacji Naukowych Wspierających Innowacyjne Terapie – BINWIT”
Dnia 7 października 2021 roku odbyła się konferencja pn. “Baza Informacji Naukowych Wspierających Innowacyjne Terapie – BINWIT”. Podczas konferencji swoje wykłady poprowadzili czołowi naukowcy zespołu realizującego Projekt BINWIT.